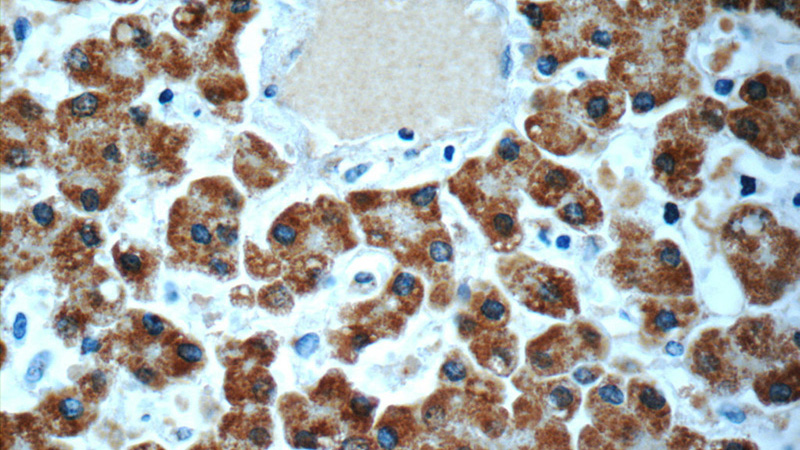
Immunohistochemistry of paraffin-embedded human liver slide using Catalog No:113686(PCCA Antibody) at dilution of 1:50

-
Product Name
PCCA antibody
- Documents
-
Description
PCCA Rabbit Polyclonal antibody. Positive IHC detected in human liver tissue. Positive IP detected in L02 cells. Positive WB detected in L02 cells, mouse liver tissue, NIH/3T3 cells. Observed molecular weight by Western-blot: 70 kDa
-
Tested applications
ELISA, WB, IHC, IP
-
Species reactivity
Human, Mouse; other species not tested.
-
Alternative names
PCCA antibody; PCCase subunit alpha antibody
-
Isotype
Rabbit IgG
-
Preparation
This antibody was obtained by immunization of PCCA recombinant protein (Accession Number: BC000140). Purification method: Antigen affinity purified.
-
Clonality
Polyclonal
-
Formulation
PBS with 0.02% sodium azide and 50% glycerol pH 7.3.
-
Storage instructions
Store at -20℃. DO NOT ALIQUOT
-
Applications
Recommended Dilution:
WB: 1:500-1:5000
IP: 1:500-1:5000
IHC: 1:20-1:200
-
Validations

L02 cells were subjected to SDS PAGE followed by western blot with Catalog No:113686(PCCA antibody) at dilution of 1:1000

Immunohistochemistry of paraffin-embedded human liver slide using Catalog No:113686(PCCA Antibody) at dilution of 1:50
Immunohistochemistry of paraffin-embedded human liver slide using Catalog No:113686(PCCA Antibody) at dilution of 1:50

IP Result of anti-PCCA (IP:Catalog No:113686, 4ug; Detection:Catalog No:113686 1:1000) with L02 cells lysate 1800ug.
-
Background
Propionyl-CoA carboxylase (PCC) catalyzes the biotin-dependent carboxylation of propionyl-CoA to D-methyl-malonyl CoA, a reaction that occurs in the mitochondrial matrix. PCC is involved in the catabolism of several essential amino acids (methionine, isoleucine, threonine and valine), as well as odd chain fatty acids and cholesterol. Deficiency of PCC results in propionic acidemia, a metabolic disorder characterized by severe metabolic ketoacidosis, vomiting, lethargy and hypotonia. PCC consists of nonidentical subunits (α and β) encoded by different genes (PCCA and PCCB, respectively). The αPCC cDNA contains an open reading frame of 2106 nucleotide bases and codes for a 702 amino acid polypeptide. The mature length subunit is 70 kDa and contains the biotin binding site.(PMID:8852656). This protein has 3 isoforms produced by alternative splicing with the molecular weight of 80 kDa, 77 kDa and 75 kDa. The full length protein has a transit peptide with 52 amino acids. This antibody is specific to PCCA.
-
References
- Guenzel AJ, Hillestad ML, Matern D, Barry MA. Effects of adeno-associated virus serotype and tissue-specific expression on circulating biomarkers of propionic acidemia. Human gene therapy. 25(9):837-43. 2014.
- Guenzel AJ, Collard R, Kraus JP, Matern D, Barry MA. Long-term sex-biased correction of circulating propionic acidemia disease markers by adeno-associated virus vectors. Human gene therapy. 26(3):153-60. 2015.
Related Products / Services
Please note: All products are "FOR RESEARCH USE ONLY AND ARE NOT INTENDED FOR DIAGNOSTIC OR THERAPEUTIC USE"
